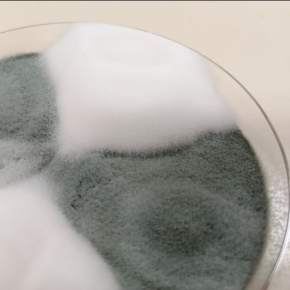
Penicillium camemberti : une histoire de domestication sur fromage

Penicillium camemberti : une histoire de domestication sur fromage
La couche blanche et cotonneuse qui recouvre le camembert est le fruit d’une sélection humaine, telle la domestication du chien à partir du loup. Une collaboration française menée par une équipe du laboratoire Ecologie, systématique et évolution - ESE (CNRS/Université Paris-Saclay/AgroParisTech) a montré, grâce à des analyses génomiques et des expériences en laboratoire, que la moisissure Penicillium camemberti est issue d’un processus de domestication qui s’est déroulé en plusieurs étapes.
Selon leurs travaux, un premier événement de domestication a donné la moisissure bleue-verte P. biforme, qui se retrouve par exemple sur les fromages frais de chèvre. Un deuxième événement de domestication, plus récent, a donné la lignée blanche et cotonneuse, P. camemberti. Les deux espèces domestiquées montrent des caractères avantageux pour l’affinage des fromages par rapport à l’espèce sauvage proche. Elles sont plus blanches et poussent plus rapidement sur le fromage en condition de cave d’affinage. D’autre part, elles ne produisent pas, ou en infime quantité, une toxine potentiellement dangereuse pour l’être humain, et elles présentent l’atout d’empêcher la prolifération de moisissures indésirables.
Ces recherches, publiées le 24 septembre dans Current Biology, peuvent avoir un impact sur la production des fromages, en aiguillant la sélection de moisissures en fonction des caractéristiques désirées.